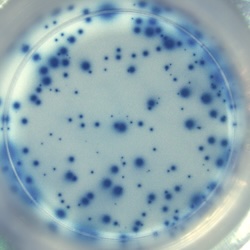
ELISPOT

ELISPOT assay applied in biomedical research
The Enzyme-linked immunospot (ELISPOT) assay was developed by Czerkinsky in 1983. The ELISPOT assay is based on and developed from a modified version of the ELISA immunoassay. It is a sensitive method for monitoring immune responses in humans and animals and a superior tool for accurate quantification of cytokine secreting T cells or antibody secreting B cells.
Nowadays, the ELISPOT assay is widely used in various fields of biomedical research, such as:
Click on the links below for more information on the application of the ELISPOT assay or the FluoroSpot assay, a modification of the T cell ELISPOT assay for the simultaneous detection of two secreted cytokines.





